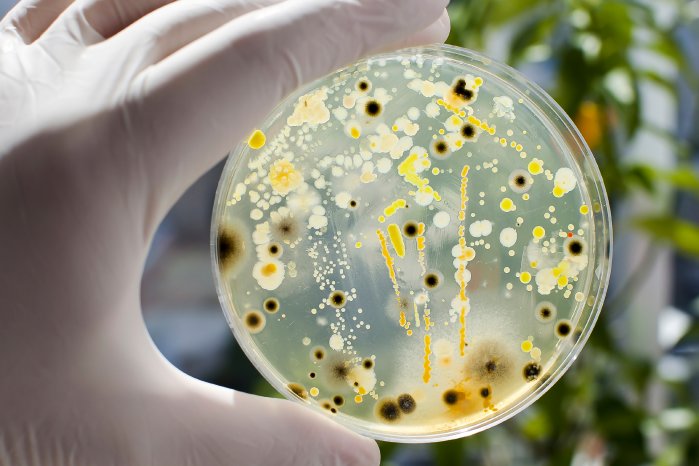
Produktionshygiene_für_ETL-_Anlagen_AdobeStock_260551176.jpeg

Zum Beispiel bilden Verkrustungen, Anhaftungen oder sonstige Rückstände an den Wandungen der Spülzonen oder im ETL- Becken ideale Lebensräume für eine Vielzahl von Mikroben. In diesen Lebensräumen vermehren sich die Mikroben und bilden durch ihre Zusammenarbeit einen eigenen Lebensraum, den Biofilm. Innerhalb diesem können sich die Mikroben ungehemmt entwickeln und schützen sich sogar gegenseitig vor äußere Einflüsse. Dies ist eine der häufigsten Infektionsquellen, denn wenn Biofilme nicht entfernt werden, können diese durch Chemikalien wie Biozide allein nicht erfolgreich bekämpft werden und führen zu einem noch größeren Wachstum.
Damit all dies Ihren Beschichtungsprozess nicht stört oder gar zu Produktionsausfall führt, ist eine grundlegende Produktionshygiene von Nöten. Dabei haben sich die folgenden Punkte bewährt:
- Grundreinigung
- Zwischenreinigung
- Kontinuierliche Maßnahmen
1. Grundreinigung
Von enormer Wichtigkeit ist die anschließende Konservierung mittels geeigneten Bioziden, nur dadurch wird eine optimale Wirkung, durch die Kombination von mechanischer und chemischer Behandlung erzielt. Dabei sind unbedingt die entsprechenden Vorgaben hinsichtlich Einsatzmengen und Einwirkzeit zu beachten.
2. Zwischenreinigung
Im Jahresverlauf und unabhängig von der Grundreinigung empfiehlt es sich bereits frühzeitig und vorbeugend Maßnahmen zur Anlagenhygiene zu ergreifen.
Daher empfehlen wir die UF-Spülzonen in einem regelmäßigen Intervall abzulassen und zu reinigen. Hierbei den Spültunnel sowie die Auffangwannen der Spülzonen intensiv mechanisch und anschließend auch chemisch zu behandeln. Das Intervall richtet sich nach dem Grad der Produktions-auslastung, dem Anlagenalter und des allgemeinen Verschmutzungsgrades, bei vielen Kunden hat sich ein 1- 3-monatiger Rhythmus bewährt.
Im Verlaufe des Jahres kann und wird es trotz aller Maßnahmen zu einem Befall durch Bakterien kommen. In diesem Fall muss frühzeitig eine Biozid- Behandlung durchgeführt werden, um ein überwucherndes Wachstum, Bildung von Biofilm und Beschichtungsproblemen vorzubeugen.
3. Kontinuierliche Maßnahmen
Die kontinuierlichen Maßnahmen beinhalten tägliche sowie wöchentliche Maßnahmen. Als erstes gehören hierzu die tägliche Bestimmung der Badwerte. Bereits hier können Anzeichen für einen möglichen Bakterien-Befall sich frühzeitig ankündigen und erkennbar sein. Insbesondere ein steigender Leitwert im Lackbecken und vor allem im Ultrafiltrat sind Indizien und Erkennungsmerkmale eines wachsenden mikrobiellen Befalls.
Zur wöchentlichen Routine gehört ebenfalls die Überwachung der Bakteriensituation mittels geeigneter Tauch- und Schalen- Nährböden. Durch die einfache Handhabung und das breite Erfassungsfeld an Bakterien haben sich DipSlides bewährt und können nach einer kurzen Einweisung von jedem durchgeführt werden. Die Beprobung sollte mindestens im Lackbecken, im Ultrafiltrat sowie der letzten Spüle vor dem ETL stattfinden und kann je nach Bedarf auf weitere Bereiche ausgeweitet werden.
Die neuen modernen und umweltfreundlicheren Lacksysteme enthalten deutlich weniger Lösemittel und können daher anfälliger für ein mögliches Bakterienwachstum sein. Die Erfahrung der letzten Jahre hat gezeigt, dass oftmals die Ultrafiltratspülzonen und VE-Spülzonen vor dem ETL der Ursprung bzw. Startpunkt vieler Bakterienbefälle war. Hier kann eine wöchentliche Konservierung der UF- Spülzonen zu einer deutlichen Verlängerung der Standzeit der ETL- Becken führen und einem schnellen Befall vorbeugen.
Wie Eingangs angeführt ist eine allgemeine Sauberkeit und Ordnung rund um die Anlage unabdingbar im Kampf gegen ständigen mikrobiellen Befall. Dies beginnt direkt in der Anlage mit der Vermeidung bzw. regelmäßigen Entfernung von Rückständen und geht in den Spülzonen weiter, in denen stehende Gewässer, Verkrustungen und Sonstiges ebenfalls vermieden bzw. regelmäßig entfernt werden sollten.
Doch auch die Bereiche rund um die Anlage, wie die Filter, Ultrafiltratbehälter und Lacknachdosierung tragen zu einem guten Gesamtergebnis bei. So sollten z.B. Verschmutzungen sofort entfernt und alte Filter entsorgt werden, um keine Brutstätte für Bakterien darzustellen.
Zusammengefasst tragen die folgenden kontinuierlichen Maßnahmen dazu bei, ein Bakterienwachstum zu vermeiden bzw. früh zu erkennen und entsprechend reagieren zu können:
- Tägliche Bestimmung der Badwerte
- Überwachung mittels Beprobung mit DipSlide
- Regelmäßige Konservierung UF- Spülzonen
- VE-Wasser Überwachung / Konservierung
- Sauberkeit rund um die Anlagen
- Letzte Spüle Vorbehandlung, kontrollieren und Verschleppungen vermeiden
Wie bereits zuvor erwähnt, lässt sich ein mikrobieller Befall selbst bei einer hervorragenden Anlagenhygiene nie komplett verhindern. Doch können die Häufigkeit und vor allem auch die Folgen durch die Anlagenhygiene und Pflege enorm beeinflusst werden.
Und für den Fall das dann doch einmal eine Konservierung durchgeführt werden muss, stehen uns mit dem Biozid-Baukasten effektive und effiziente Gegenmittel zur Hand. Die Biozide wurden alle entsprechend im FreiLacke Labor auf den Einsatz im ETL- Bereich geprüft und freigegeben. Durch die mögliche Kombination von verschiedenen Wirkstoffen kann ein weites Feld an diversen Bakterien, Hefen und Pilzen bekämpft und möglichen Adaptionen vorgebeugt werden.
Bei allen Bioziden ist unbedingt darauf zu achten, die Einwirkzeit von mindestens 48 Stunden einzuhalten. In dieser Zeit darf keine Produktion erfolgen, da durch die Anlegung von Spannung und den Beschichtungsprozess die Biozide in ihrer Wirkung gestört und unbrauchbar werden.
Grundlegend hat sich eine Einsatzmenge von 0,2% bezogen auf das Beckenvolumen bewährt. In besonderen Fällen können auch mal größere bzw. auch kleinere Mengen sinnvoll sein und sollten immer mit der AWT FreiLacke abgesprochen werden.
Hygiene- Audit – der Gesundheitscheck für die Anlage
Nur wer versteht, wo die Ursachen liegen und diese erkennt, kann gezielt vorgehen und Probleme lösen. Wir als FreiLacke stehen auch hier unseren Kunden mit unserem umfangreichen Service zur Seite. Daher unterstützen wir unsere Kunden gerne bei Anlagenreinigungen, Konzepten zur vorbeugenden Wartung oder der Ursachenanalyse mittels eines Hygiene Audits.
Bei letzterem handelt es sich um einen „Gesundheitscheck für die Anlage“, bei dem der gesamte Prozess hinsichtlich mikrobiologischen Befalls auf den Prüfstand gestellt wird.
Bei einem Hygiene Audit erfolgt eine systematische Überprüfung der verschiedenen Zonen, angefangen von der Vorbehandlung bis hin zur letzten Spüle nach der ETL- Beschichtung.
Hierbei werden zum einen die Prozessflüssigkeiten beprobt und zum anderen Abstriche von Wandungen, Hinterschneidungen, Abdeckblechen und Ablagerungen entnommen. All diese Proben werden anschließend auf Nährböden aufgestrichen und in einem Fachlabor auf aerobe / anaerobe Bakterien sowie Hefen und Pilze untersucht.
Mit Hilfe eines solchen „Gesundheitscheck für die Anlage“ entsteht eine klare Übersicht und ein tieferes Verständnis der möglichen Brandherde und Ausgangspunkte für immer wieder auftretende Verkeimungen. Zudem lassen sich durch ein systematisch durchgeführtes Hygiene Audit Handlungsfelder ableiten und gezielte Maßnahmen ergreifen, um ständiger Verkeimung vorzubeugen und für einen stabilen und qualitativ hochwertigen Beschichtungsprozess zu sorgen.